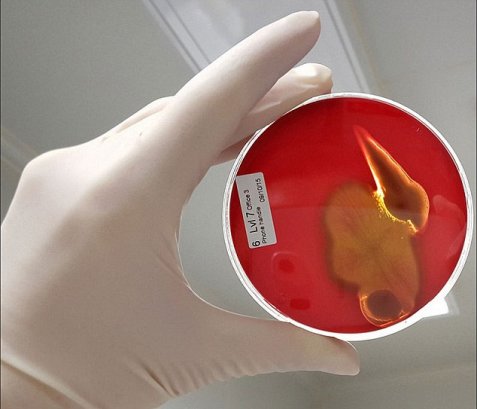
image
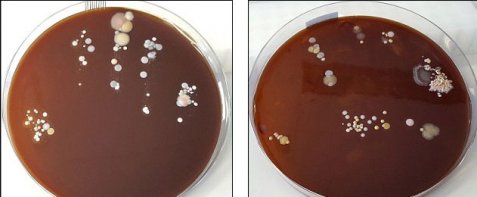
image
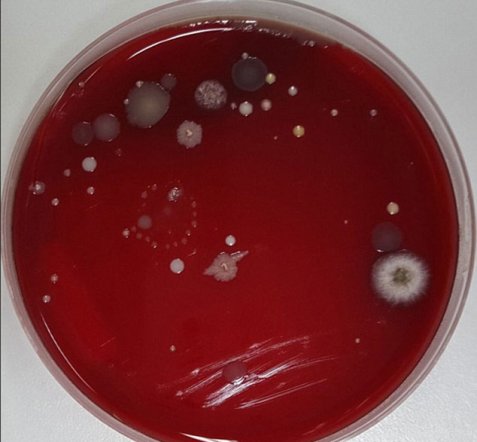
image
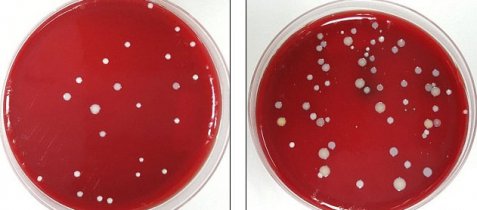
image

- CITY GUIDE
- PODCAST
-
17°
Βόμβες μικροβίων το πληκτρολόγιο, το τηλέφωνο και το κουμπί του ασανσέρ (εικόνες)
Τι έδειξε έρευνα του πανεπιστημίου του Κουίνσλαντ
Αν δουλεύετε σε γραφείο, τότε θα πρέπει να το σκεφτείτε δύο φορές πριν επιχειρήσετε να φάτε πάνω σε αυτό.
Οι επιφάνειες γύρω από υπολογιστές και τηλεφωνικές συσκευές αποδεικνύονται σε μερικά από τα πιο ανθυγιεινά μέρη στον χώρο εργασίας.
Συγκεκριμένα, έρευνα του πανεπιστημίου του Κουίνσλαντ έδωσε στη δημοσιότητα κάποιες σοκαριστικές φωτογραφίες από μικρόβια και βακτηρίδια που βρέθηκαν σε επιφάνειες σε εργασιακό χώρο.
Οι πιο βρομερές αποδείχθηκαν πως είναι ο πάγκος της κοινόχρηστης κουζίνας στο γραφείο και τα πληκτρολόγια, ενώ στα καθαρότερα συγκαταλέγονται τα πόμολα, τα γραφεία και οι καρέκλες.
Σύμφωνα με τον επικεφαλής της έρευνας Δρ. Ματ Κούπερ, ο οποίος μίλησε στην αυστραλιανή έκδοση της Daily Mail, είναι σημαντικό ο κόσμος να καταλάβει πως ο καλύτερος τρόπος για να αποφύγουν την επαφή με τα μικρόβια είναι να πλένουν συχνά τα χέρια τους με σαπούνι και νερό και να μην καταφεύγουν στα λεγόμενα αντιμικροβιακά τζελ, που κυκλοφορούν στην αγορά.
Ο Δρ. Κούπερ ανέφερε πως η δημοσιοποίηση των εικόνων με τα ευρήματα της έρευνας σε χώρους εργασίας, έχει στόχο να κινητοποιήσει τον κόσμο και να τον κάνει να εντάξει στην καθημερινότητά του το συχνό πλύσιμο των χεριών κατά τη διάρκεια της ημέρας.

Δείγμα από ακουστικό τηλεφωνικής συσκευής σε χώρο εργασίας
Δείγμα από ακουστικό τηλεφωνικής συσκευής σε χώρο εργασίας
Δείγματα από χέρια εργαζόμενων σε γραφείο

Δείγμα από χέρι εργαζόμενου που δεν έπλενε τα χέρια του, αλλά χρησιμοποιούσε αντιμικροβιακό τζελ
Δείγμα από επιφάνεια γραφείου αποκαλύπτει πως έχει λιγότερα βακτήρια από ένα ακουστικό τηλεφώνου
Το εξωτερικό κουμπί ανελκυστήρια έχει λιγότερα μικρόβια από το εσωτερικό
ΤΑ ΠΙΟ ΔΗΜΟΦΙΛΗ
ΔΙΑΒΑΖΟΝΤΑΙ ΠΑΝΤΑ
ΔΕΙΤΕ ΕΠΙΣΗΣ
Με αυτόν τον τρόπο, εισέπραττε περίπου 1.000 λίρες τον μήνα
Η αλλαγή που φαίνεται… και εξηγείται
Το ζευγάρι είχε επιλέξει συνειδητά να μην αφαιρεί καμία τρίχα από το σώμα του τα τελευταία χρόνια
Ο κλήρος έπεσε σε έναν 58χρονο από το Παρίσι - Τα έσοδα από δημοπρασία πάνε για καλό σκοπό
Το πολιτικό μήνυμα πίσω από την κίνηση αυτή
O πρόεδρος έδωσε όπως αναφέρεται ένα γενναίο φιλοδώρημα
Βίντεο και σχόλια στα social media κατέγραψαν την αμηχανία
Το βίντεο που κάνει τον γύρο του διαδικτύου
Το βίντεο που κάνει τον γύρο του διαδικτύου
Το βίντεο που κάνει τον γύρο του διαδικτύου
Το βίντεο που κάνει τον γύρο του διαδικτύου
Η ελληνοαμερικανίδα ηθοποιός μιλά για το πώς η καθημερινότητα έγινε κωμωδία και η ελληνίδα μάνα έγινε διάσημη στα social media
Το λαμπερό ζευγάρι του Χόλιγουντ βρέθηκε ανάμεσα στους πιστούς στον Άγιο Κωνσταντίνο
Δημιουργήθηκε για να εξυπηρετεί τους πεζούς
Μια μικρή γκάφα στο μοντάζ έγινε αμέσως viral
Από λαγουδάκια-κριτές φρεσκάδας μέχρι σοκολατένιες αποδράσεις και broccoli attitude
Οι συνθήκες που οδήγησαν στο περιστατικό παραμένουν αδιευκρίνιστε
Η viral στιγμή από το μακρινό διάστημα θεωρήθηκε η καλύτερη διαφήμιση
H αποκάλυψη έγινε... πάνω από το φέρετρο του
Γέλια και χειροκροτήματα μετά την πρωτότυπη ανακοίνωση του Κρητικού πιλότου
Έχετε δει 20 από 200 άρθρα.